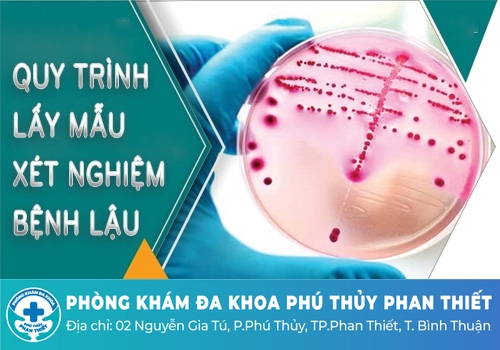

Công ty TNHH MTV dịch vụ y tế Phú Thủy Phan Thiết
02 Nguyễn Gia Tú, Khu phố 14, Thành phố Phan Thiết, Bình Thuận
Liên lạc: 0252 7303 888
Để có thể hỗ trợ điều trị bệnh lậu hiệu quả và tiết kiệm thời gian chi phí thì cơ sở lựa chọn là yếu tố chiếm phần đặc biệt quan trọng. Thế nhưng trước thực tế phũ phàng khi phải đứng trước quá nhiều sự lựa chọn rẻ thì không đảm bảo, mắc hơn lại không đủ khả năng… Nhiều bệnh nhân vốn đã khó khăn vì bệnh tật nay lại càng càng phiền muộn hơn. Cùng chúng tôi tìm hiểu về phòng khám chữa bệnh lậu tại Bình Thuận để có thêm gợi ý hữu ích!
Bệnh lậu do vi khuẩn Neisseria gonorrhoeae gây ra, đây là một dạng vi khuẩn song cầu Gram (-), chúng thường có mặt ở những nơi chứa nhiều dịch tiết của cơ thể. Trong đó, lậu là bệnh nhiễm trùng lây qua đường âm đạo, miệng hoặc hậu môn với người bị nhiễm bệnh qua quan hệ.
Khám chuyên khoa lậu là khám những gì là một trong những thắc mắc của nhiều người. Khám lậu là thực hiện các xét nghiệm cận lâm sàng nhằm xác định chính xác để biết bạn có bị nhiễm lậu hay không. Dưới đây là những xét nghiệm phổ biến hiện nay để chẩn đoán bệnh lậu:

➣ Xét nghiệm nuôi cấy vi khuẩn: Mẫu vật phẩm là dịch được lấy từ âm đạo, niệu đạo, trực tràng, mắt, cổ họng,... của người bệnh nghi ngờ mắc bệnh lậu, sau đó được nuôi cấy trong môi trường thuận lợi của loại vi khuẩn này. Trong khoảng thời gian định, nếu trong mẫu bệnh phẩm có vi khuẩn lậu thì chúng sẽ sinh sôi, nhân lên số lượng nhanh chóng và có thể xác định được. Xét nghiệm nuôi cấy vi khuẩn không chỉ để chẩn đoán bệnh lậu mà còn giúp bác sĩ xây dựng kháng sinh đồ, từ đó lựa chọn kháng sinh hỗ trợ điều trị phù hợp, tránh gây tình trạng kháng thuốc hoặc hỗ trợ điều trị không hiệu quả.
➣ Xét nghiệm nhuộm gram tìm lậu cầu: Nhuộm gram là kỹ thuật sử dụng thuốc nhuộm chuyên biệt để làm nổi bật vi khuẩn lậu cầu, giúp quan sát dễ dàng hơn dưới kính hiển vi. Mẫu bệnh phẩm sử dụng trong xét nghiệm này là mẫu dịch niệu đạo, dịch ở âm đạo, cổ tử cung. Với xét nghiệm nhuộm gram chẩn đoán bệnh lậu này, thời gian phân tích khá nhanh, kết quả có thể có trong 30 - 45 phút.
➣ Xét nghiệm PCR: Xét nghiệm PCR là kỹ thuật xét nghiệm cho kết quả nhanh, có thể chẩn đoán bệnh ở giai đoạn sớm. Mẫu bệnh phẩm được sử dụng là dịch niệu đạo ở nam giới, nước tiểu đầu dòng ở nam giới hoặc dịch âm đạo của nữ giới. Độ nhạy và độ đặc hiệu của xét nghiệm này đạt tới khoảng 98%, được đánh giá là xét nghiệm chính xác và có thể phát hiện sớm bệnh lậu. Phương pháp này phù hợp với những bệnh nhân nghi ngờ mắc bệnh lậu nhưng chưa có triệu chứng.
Quy trình xét nghiệm bệnh lậu đạt chuẩn, chuyên nghiệp từ A-Z gồm các bước sau:
✜ Thăm khám lâm sàng
Trước khi thực hiện xét nghiệm, người bệnh cần thực hiện một bước vô cùng cần thiết trong quy trình là thăm khám lâm sàng. Bác sĩ sẽ hỏi bệnh nhân một số thông tin liên quan đến bệnh: tiền sử bệnh lý, thói quen quan hệ, thời gian xuất hiện triệu chứng từ bao giờ,… và sau đó là thăm khám bệnh để được ra chẩn đoán ban đầu và chỉ định những xét nghiệm phù hợp cho từng trường hợp.
✜ Lấy mẫu xét nghiệm
Mẫu bệnh phẩm dùng để làm xét nghiệm chẩn đoán bệnh lậu thường được lấy từ dịch niệu đạo, âm đạo, nước tiểu hoặc dịch rỉ mắt tùy thuộc vào từng trường hợp riêng.
• Lấy dịch niệu đạo nam: Dịch niệu đạo nam nên lấy vào buổi sáng trước khi đi tiểu, dùng hai que tăm bông (1 tăm bông để nuôi cấy, 1 để soi trực tiếp). Dùng tăm bông vô trùng đưa vào niệu đạo khoảng 2-3 cm, xoay tròn và để trong đó khoảng 5 giây rồi rút tăm bông ra.
• Lấy dịch âm đạo phụ nữ: Bệnh phẩm dịch âm đạo ở nữ giới chủ yếu lấy ở niệu đạo và cổ tử cung. Dùng hai que tăm bông, hoặc que cấy (1 để nuôi cấy, 1 để soi trực tiếp). Dùng que cấy hoặc tăm bông vô trùng đưa sâu vào cổ tử cung, xoay tròn tăm bông ở các vị trí cổ tử cung và để giữ nguyên 5-10 giây rồi rút ra.
• Nước tiểu đầu dòng vào buổi sáng: Để cho bệnh nhân nhịn tiểu suốt đêm (lấy nước tiểu vào buổi sáng) hoặc có thể nhịn tiểu sau 3 giờ. Trước khi lấy mẫu bệnh phẩm nước tiểu cần rửa sạch vùng kín ngoài bằng dung dịch rửa. Sau đó, lấy đoạn đầu nước tiểu vào lọ ống nghiệm miệng rộng đã vô trùng, không lấy nước tiểu qua bô.
Đăng ký xét nghiệm bệnh lậu TẠI ĐÂY với bác sĩ chuyên khoa bệnh lậu.
Hầu hết, tâm lý chung của mọi người sẽ muốn thăm khám tại các cơ sở y tế chuyên khoa uy tín, nhanh chóng, hiệu quả và bảo mật kín đáo. Thấu hiểu được mong muốn đó từ đa số khách hàng, Phòng Khám Đa Khoa Phú Thủy Phan Thiết đã ra đời, xây dựng mô hình thăm khám theo tiêu chuẩn quốc tế. Đảm bảo mang đến sự hài lòng cho hầu hết khách hàng, khắc phục các hạn chế còn tồn tại ở các cơ sở y tế công lập.
.jpg)
✫ Đội ngũ bác sĩ: Đều là những người có gần 40 năm kinh nghiệm, kỹ năng chuyên môn giỏi, sẽ trực tiếp thăm khám, xét nghiệm và đưa ra phương pháp hỗ trợ điều trị phù hợp. Nhiều năm qua đội ngũ y bác sĩ đã không ngừng nỗ lực nghiên cứu và ứng dụng các phương pháp hỗ trợ chữa bệnh khoa học, nhận được phản hồi tích cực từ phía bệnh nhân.
✫ Hệ thống cơ sở vật chất được chú trọng đầu tư: Các phòng ban được xây dựng tách biệt, đảm bảo vô khuẩn và hạn chế tình trạng lây nhiễm bệnh chồng chéo. Đầu tư máy móc hiện đại, phục vụ cho quá trình xét nghiệm và hỗ trợ điều trị bệnh chính xác.
✫ Dịch vụ y tế chuyên nghiệp: Mọi thông tin hồ sơ bệnh án đều được bảo mật theo đúng quy định. Đặc biệt Phòng khám triển khai hệ thống đặt lịch khám trực tuyến, hẹn giờ trước. Tránh tình trạng đông đúc, người khám không phải đợi lâu và tránh chạm mặt với nhiều người.
✫ Ứng dụng liệu pháp hỗ trợ điều trị bệnh hiện đại: Bên cạnh việc sử dụng nhuần nhuyễn các kỹ thuật xét nghiệm bệnh lậu, Đa Khoa Bình Thuận còn tiên phong ứng dụng liệu pháp điện trường DHA – phương pháp hỗ trợ điều trị bệnh lậu. Nguyên lý hoạt động của liệu pháp này là sử dụng điện trường sản sinh ở tần số cao nhằm tác động và ức chế sự phát triển của vi khuẩn lậu. Từ đó giúp loại bỏ vi khuẩn dễ dàng và kích hoạt hệ thống miễn dịch, giúp sức khỏe bệnh nhân mau chóng hồi phục.
Mong rằng với những chia sẻ ở bài viết đã giúp bạn đọc hiểu rõ hơn về việc đi khám chuyên khoa lậu. Từ đó, chủ động trong việc thăm khám và hỗ trợ điều trị bệnh đúng thời điểm, nhằm hỗ trợ giảm các biến chứng khôn lường cho sức khỏe. Để được đặt lịch thăm khám, vui lòng chat tại mục [TƯ VẤN TRỰC TUYẾN] hoặc gọi đến Hotline: 0252 7303 888 để được các chuyên gia hỗ trợ nhanh .
Phòng Khám Đa Khoa Phú Thủy Phan Thiết địa chỉ: 2 Nguyễn Gia Tú, Phú Thuỷ, Thành phố Phan Thiết, Bình Thuận
- Đặt lịch hẹn qua số điện thoại: 0252 7303 888 để được đăng ký khám sớm không mất công chờ đợi.
- Đăng ký ngay để nhận tư vấn và dịch vụ ưu đãi: